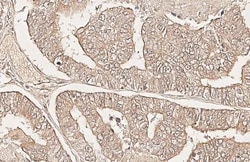
Invitrogen CXCR6 Recombinant Rabbit Monoclonal Antibody (HL3144) 100 &mu;L;

missing translation for 'onlineSavingsMsg'
Learn More
Learn More
Invitrogen™ CXCR6 Recombinant Rabbit Monoclonal Antibody (HL3144)


Rabbit Recombinant Monoclonal Antibody
Brand: Invitrogen™ MA556667
This item is not returnable.
View return policy
Description
CXCR6 Recombinant Monoclonal Antibody for IHC (P)
CD186, also known as CXCR6, is a G protein-coupled chemokine receptor reported to be one of the cellular receptors of HIV and SIV. CD186 is expressed by NKT cells, various subtypes of T cells with activated and memory phenotypes, and some plasma cells. It has been reported that mouse liver NK cells, but not naïve or splenic NK cells, express CD186. The ligand of CD186, CXCL16, is expressed by macrophages, dendritic cells and liver endothelial cells. Being highly expressed on NKT cells, CD186 is often used as a proxy marker of this cell subset.
Specifications
| CXCR6 | |
| Recombinant Monoclonal | |
| 1 mg/mL | |
| PBS with no preservative | |
| O00574 | |
| CXCR6 | |
| Synthetic peptide encompassing a sequence within the Intracellular domain of human CXCR6. The exact sequence is proprietary. | |
| 100 μL | |
| Primary | |
| Human | |
| Antibody | |
| IgG |
| Immunohistochemistry (Paraffin) | |
| HL3144 | |
| Unconjugated | |
| CXCR6 | |
| BB217514; BONZO; C Cmotif chemokine; C X C motif chemokine; CC motif chemokine; CCmotif chemokine; CD186; CD186 antigen; CDw186; chemokine (C-X-C motif) receptor 6; chemokine receptor CXCR6; CXC; C-X-C chemokine receptor type 6; CXC motif chemokine; C-X-C motif chemokine receptor 6; Cxcr6; CXC-R6; CXCR-6; G protein-coupled receptor; G-protein coupled receptor bonzo; G-protein coupled receptor STRL33; OTTHUMP00000209997; OTTHUMP00000209998; STRL33; TYMSTR | |
| Rabbit | |
| Protein A | |
| RUO | |
| 10663 | |
| -20°C, Avoid Freeze/Thaw Cycles | |
| Liquid |
Product Content Correction
Your input is important to us. Please complete this form to provide feedback related to the content on this product.
Product Title
Spot an opportunity for improvement?Share a Content Correction